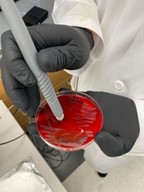

About the Lab
Our laboratory specializes in the development and application of direct mass spectrometry technologies for tissue analysis and disease detection. Our research focuses on identifying metabolic markers associated with cancer and other diseases, as well as designing innovative mass spectrometry–based technologies and medical devices for clinical and surgical applications.
We integrate expertise in chemistry, mass spectrometry, statistical analysis, machine learning, and device prototyping and engineering to address complex challenges in biomedical research and to develop transformative technologies aimed at improving patient care.
A central goal of our work is to enhance clinical decision-making in cancer diagnosis and surgery by providing clinicians with near–real-time, disease-predictive metabolic information. In parallel, we seek to deepen the understanding of disease progression, prognosis, and therapeutic strategies.
One of our flagship innovations, the MasSpec Pen, has been featured on the television series Grey’s Anatomy and is currently being evaluated by surgeons at the Texas Medical Center. In addition, we develop advanced mass spectrometry imaging technologies to spatially characterize molecular composition in tissues and other challenging clinical samples.
Our research is supported by funding from the Marcus foundation, National Institutes of Health, and other medical and research foundations.
Lab team members

Mass Spectrometry of Tissues for Biomarker Discovery
We have developed several methods using desorption electrospray ionization (DESI) MS imaging to improve specificity in the detection and imaging of hundreds of metabolites and lipids directly from human tissue sections.

Development of Diagnostic Methods for Clinical Use
Using DESI-MS imaging and other direct MS techniques, we are optimizing experimental protocols and data analytics to maximize molecular coverage and sensitivity to detect diagnostic molecules from patient samples that have complex cellular and molecular composition.

Intraoperative and Medical Mass Spectrometry
Our team has made significant contributions to the field of in vivo MS analysis by developing and translating MS systems to the operating room, thereby enabling in vivo molecular measurements of the dynamic metabolic information that can help stratify disease and guide treatment decisions for patients in real time.
Rapid Identification of Infectious Diseases
We are particularly interested in using the MasSpec Pen technology to look at molecular signatures of clinically relevant bacteria and identify markers to antibiotic resistant.

Advanced Data Analytics and Statistical Methods
Our lab has developed many data analysis workflows adapting and integrating sophisticated statistical methods to evaluate complex molecular datasets that we obtain with MS technologies.
The MasSpec Pen
Recent Publications
Hiram Subhra Base, Meredith Spradlin, Tian Weihua, Jose Enriquez, Pratip Bhattacharya, Livia S. Eberlin, "Glutaminase inhibitors block metabolic switch in prostate cancer and prevents anti-androgen treatment resistance", Cancer Res (2023) 83 (7_Supplement): 6035.
Mary E. King, Monica Lin, Meredith Spradlin, and Livia S. Eberlin, "Advances and Emerging Medical Applications of Direct Mass Spectrometry Technologies for Tissue Analysis", Annual Review of Analytical Chemistry, 2023.
Principal Investigator
Dr. Livia Eberlin’s research program centers around the development and application of novel mass spectrometry technologies in health-related research.

Events and Outreach
Cutting Loose Social painting competition.

In the News
- Handy ‘MasSpec Pen’ collection could help detect opioids from the skin - June 24, 2025
- Eberlin Lab receives $3 million grant from The Marcus Foundation - Jan. 3, 2024
- The MasSpec Pen offers the power of real-time tissue identification during surgery - Aug. 29, 2023
- Dr. Eberlin Awarded NIH Grant to Study Alzheimer’s - Oct. 20, 2022
- Baylor Researchers Awarded $1.6M to Investigate Mass Spec Test for Thyroid Cancer - April 18, 2022










